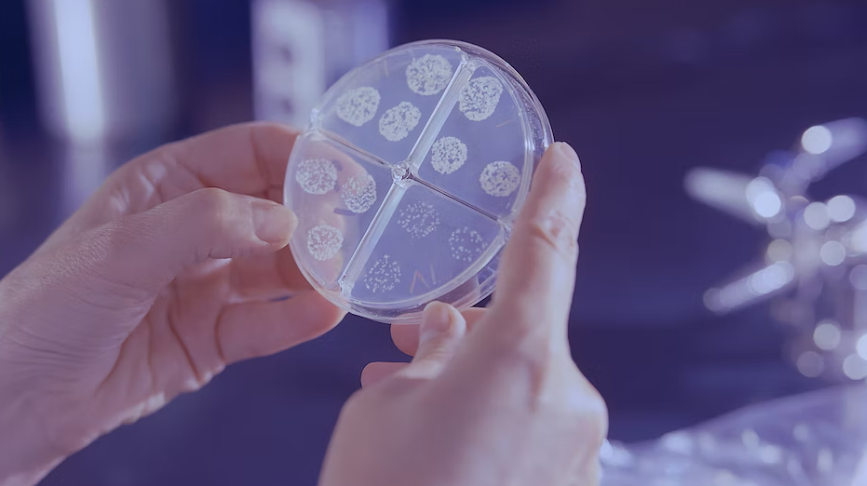

소변은 우리 신체상태를 반영하는 가장 중요한 지표 중 하나입니다. 비록 소변에 있는 미생물 같은 것들은 우리가 건강하고 안전하게 살 수 있는 중요한 요소라고 할 수 있습니다. 따라서 소변을 주기적으로 검사하는 것은 매우 중요합니다.
이번 포스팅 에서는 소변에 대한 기본적인 정보를 다루고 소변에 따른 건강 상태를 살펴보고자 합니다. 소변의 색깔과 상태를 관찰함으로써 우리가 느끼는 건강 문제를 좀 더 잘 이해할 수 있습니다.
소변이란?

소변은 특정 신체 상태를 반영하는 중요한 지표 중 하나입니다. 소변은 우리 신체가 생산하는 자연적인 물질로 이루어져 있습니다. 또한 소변에는 각종 미생물들도 포함되어 있습니다. 소변은 우리가 건강하고 안전하게 살 수 있는 중요한 요소로 여겨집니다.
소변의 색깔

소변의 색깔은 건강 상태를 점검하는 중요한 요소입니다. 소변의 색깔은 우리의 신체 상태를 알려주는 가장 일반적인 지표 중 하나입니다. 소변의 색깔을 정확하게 인식하기 위해서는 소변의 특성을 잘 이해해야 합니다. 소변의 색깔은 주로 녹색, 노란색, 회색, 흑색이 있습니다.
녹색 소변

녹색 소변은 가장 일반적인 소변 색깔 중 하나입니다. 이는 신체가 정상적인 상태라는 것을 의미합니다. 녹색 소변의 색깔은 신체가 정상적인 상태인지 검사하는 좋은 방법으로 사용될 수 있습니다. 녹색 소변을 보면 신체가 가지고 있는 미생물이 정상적으로 작동하고 있다는 것을 의미합니다.
노란색 소변

노란색 소변은 우리가 건강하지 않은 상태를 식별하는 중요한 지표 중 하나입니다. 노란색 소변은 신체가 감염되었다는 것을 시그널로 보내는 것입니다. 노란색 소변의 색깔은 다양할 수 있습니다. 또한 노란색 소변의 색깔은 신체가 무리하게 작동하고 있다는 것을 나타내는 것도 있습니다.
회색 소변
회색 소변은 신체가 이상한 상태라는 것을 의미합니다. 신체가 부적합한 상태라는 것을 나타내는 것도 있습니다. 회색 소변은 신체 내 미생물이 불균형이 되어있다는 것을 뜻합니다. 또한 회색 소변은 신체 내에 불균형이 있는 다른 질환의 징후로도 여겨집니다.
흑색 소변

흑색 소변은 신체가 악성 병변을 가지고 있다는 것을 의미합니다. 흑색 소변은 다양한 질병의 징후로도 여겨집니다. 또한 흑색 소변은 다양한 약물의 중독 또는 다른 종류의 감염의 징후로도 볼 수 있습니다.
빨간색 소변

빨간색 소변은 신체가 혈관 손상을 입었다는 것을 의미합니다. 신체 내 혈관이 손상되면 소변에는 빨간색의 색깔이 나타납니다. 이는 신체가 외부 원인으로 인해 손상되었다는 것을 의미합니다. 빨간색 소변은 다른 질환의 징후로도 여겨집니다.
백색 소변

백색 소변은 신체가 감염되거나 염증이 발생하는 경우 생기는 소변 색깔 중 하나입니다. 신체가 염증을 가지고 있다면 소변에는 백색의 색깔이 나타납니다. 백색 소변은 신체가 감염되었다는 것을 나타내는 것도 있습니다.
결론
소변은 우리 신체 상태를 반영하는 가장 중요한 지표 중 하나입니다. 소변의 색깔과 상태를 관찰함으로써 우리가 느끼는 건강 문제를 좀 더 잘 이해할 수 있습니다. 소변은 우리가 건강하고 안전하게 살 수 있는 중요한 요소로 여겨집니다. 따라서 주기적으로 소변을 검사하는 것은 매우 중요합니다.

